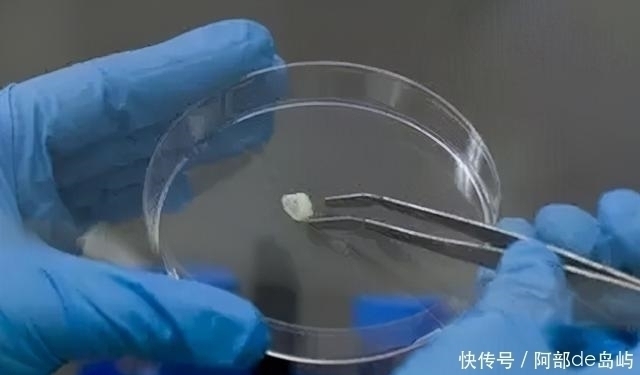
国际分子科学杂志|惊!小小乳牙竟能治疗多种疾病?爸爸妈妈别再丢掉它

国际分子科学杂志|惊!小小乳牙竟能治疗多种疾病?爸爸妈妈别再丢掉它
日本大阪牙科大学在《国际分子科学杂志》发表了一篇报告,表示,牙髓干细胞不仅能治疗牙病,还能治其他病。
一时间,哗然一片,当真?

文章插图
牙髓干细胞来自于牙齿。2000年,Gronthos 等科学家从脱落的儿童乳牙中发现了牙髓干细胞。3 年后,Miura 等研究者从中分离出乳牙干细胞。

文章插图
想想看你小时候脱落的乳牙,是不是扔到床底啦,房顶啦,甚至不小心吞咽了。
但科学家们2000年的这项发现,传递出这颗乳牙不简单的信号。
于是立即展开研究,从乳牙中分离出干细胞。再进行实验后发现,“乳牙干细胞”具备强大的自我更新和多向分化潜能。
它在特定诱导条件下,可以分化为神经细胞、脂肪细胞、软骨细胞、骨细胞、肌腱细胞、肝细胞、心肌细胞、胰岛β细胞、肌肉细胞等,在医学领域应用前景广阔。
首先,既然它来自于牙齿,那能不能治牙病?
这个答卷几乎满分。乳牙干细胞大显身手,让坏牙“起死回生”。

文章插图
2018年8月,金岩、施松涛、轩昆、李蓓和郭浩等科学家在《Science Translational Medicine》发表了一项研究成果。经过20年的努力,我们终于破解了牙“死亡”的世界级医学难题。成功实现牙髓再生,更在国际上首创牙髓再生手术,给“死亡”牙齿赋予新“生命”。
所以,乳牙干细胞在牙病领域的能力毋庸置疑。
但现在,日本科学家表示,除了牙病,其他病也有用!
我们来一看究竟。
日本大学的这篇报告显示,对多种疾病都有明显效果。
脊髓损伤:乳牙干细胞移植机能性地恢复了脊髓损伤。
脑出血:在对大鼠的对比研究中发现,相比骨髓间充质干细胞,乳牙干细胞减少的梗死体积更大,也就是治疗效果更好。
糖尿病:乳牙干细胞减少了胰腺损伤,改善了肾功能和疼痛性糖尿病神经病变。
帕金森症:将乳牙干细胞移植到帕金森症大鼠后,可改善它们的行为障碍。
以及阿尔茨海默症、心肌梗死、肌肉萎缩症、肝病、眼病、免疫性疾病。
文章插图
目前,世界范围内乳牙干细胞已经被用于牙髓再生、牙周再生、中枢神经系统损伤、神经退行性疾病、眼角膜再生、心肌梗死、肝纤维化、类风湿关节炎、骨和软骨再生、杜氏肌营养不良、系统性免疫性疾病、内分泌疾病、急性呼吸窘迫症、自身免疫性脑脊髓炎和急性肾衰等疾病的治疗研究。
这颗小小的乳牙当真是个宝,为现代医学的发展注入新力量。
【 国际分子科学杂志|惊!小小乳牙竟能治疗多种疾病?爸爸妈妈别再丢掉它】那对于普通人,该如何利用自己或小孩的乳牙呢?还是丢到垃圾桶,房顶上吗?
不要这样做,太可惜。
中国科学院院士吴祖泽曾说:“人们应该从小保存自己脱落的牙齿,因为这些牙齿里包含珍贵的牙髓干细胞,可用于干细胞治疗。”
这里的保存可不是放冰箱,而是从脱落的乳牙获取乳牙干细胞,通过专业的技术分离扩增,并长期保存在深低温环境。
当孩子处于6—7岁的换牙期,你可以考虑将他的乳牙储存下来。错过孩子换牙期,就失去了这份珍贵资源。
- 因为|双胞胎一个被送去国际幼儿园,另一个上普通幼儿园,差距有多大?
- 什么|这些谣言你都听过吗?妈妈网孕育破解网传谣言,帮你科学助孕
- 崔玉涛推荐【月子手册】42天科学坐月子
- 科学育儿有讲究,孕期怎么吃,生出的宝宝才漂亮又健康呢
- 脑科学家证实:经常催孩子,孩子会越来越笨,到底有多可怕
- 儿童面条怎么选,家长要避开噱头,科学选择并为宝宝健康保驾护航
- 孕期|国际最新研究:孕期感染新冠病毒或不会感染胎盘组织从而保护胎儿
- 妈妈,你为什么这么焦虑?因为上了“科学”育儿的当
- 疫情|科学防疫丨疫情防控再提示
- 师范|安徽2022单招校考指导|阜阳幼儿师范高等专科学校
